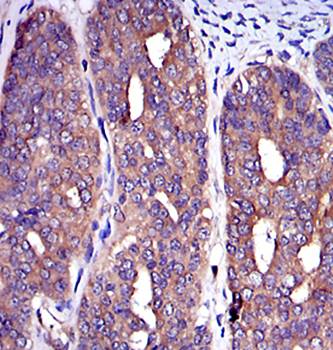
C-CBL Antibody

You have no items in your shopping cart.
All Products
- Featured
c-Jun Antibody [orb97352]Featured
FC, ICC, IHC, WB
Human, Monkey, Mouse
Mouse
Monoclonal
Unconjugated
100 μl - Featured
C-CBL Antibody [orb97356]Featured
FC, ICC, IHC, WB
Human, Mouse, Rat
Mouse
Monoclonal
Unconjugated
100 μl - Featured

- Featured

- Featured
MAPK3 Antibody [orb97367]Featured
FC, ICC, IHC, WB
Human, Monkey, Mouse, Rat
Mouse
Monoclonal
Unconjugated
100 μl - FADS2 Antibody (N-term) [orb1937594]
FC, IF, IHC-P, WB
Human
Monkey
Rabbit
Polyclonal
Unconjugated
100 μl, 50 μl - IL1A Antibody (Center) [orb1929753]
FC, IHC-P, WB
Human, Mouse
Rabbit
Polyclonal
Unconjugated
50 μl, 100 μl - Phospho-CDC25A(S124) Antibody [orb1931290]
IHC-P, WB
Human, Mouse, Rat
Rat
Rabbit
Polyclonal
Unconjugated
100 μl, 50 μl - Glucagon Antibody (C-term) [orb1929798]
FC, IF, IHC-P, WB
Human, Mouse, Rat
Rabbit
Polyclonal
Unconjugated
100 μl, 50 μl